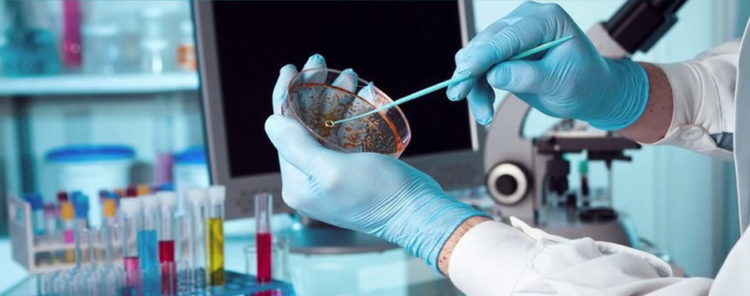

Shkruan: Doc. Dr. Snezhana Iviq-Kolevska
Mikrobiologe
Përgatitja e pacientëve për marrjen e mostrave për testim mikrobiologjik ka një rëndësi të veçantë, pasi që mund të ndikojë ndjeshëm në rezultatet e ekzaminimit.
Të gjitha mostrat duhet të merren para fillimit të terapisë me antibiotikë ose disa ditë (të paktën 48 orë) pas ndërprerjes së trajtimit.
 BRIS NGA FYTI (faringu) duhet të merret në mëngjes, para se të lani dhëmbët ose para se të merrni ushqim dhe ujë. Nëse merret gjatë ditës, duhet që të paktën të kenë kaluar 2 orë nga vakti ushqimor i fundit.
BRIS NGA FYTI (faringu) duhet të merret në mëngjes, para se të lani dhëmbët ose para se të merrni ushqim dhe ujë. Nëse merret gjatë ditës, duhet që të paktën të kenë kaluar 2 orë nga vakti ushqimor i fundit.
 BRISI NGA HUNDA duhet të merret para terapisë me antibiotikë dhe të paktën 3-4 orë pas pastrimit të fundit ose fryrjes së hundës. Më së miri do të ishte që për ekzaminim mikrobiologjik të mblidhni sekret nga hunda, veçanërisht nëse është i dendur dhe me ngjyrë, pasi që është tipike për infeksion bakterial, ndryshe nga sekreti i tejdukshëm dhe i hollë që zakonisht transmeton infeksionin viral. Gjatë marrjes së brisit nga fyti dhe hunda te fëmijët, prindërit duhet ta mbajnë fëmijën në prehër, të vendosin njërën dorë te duart e fëmijës, ndërsa dorën tjetër te balli duke e mbajtur kështu kokën derisa personi adekuat i merr bris.
BRISI NGA HUNDA duhet të merret para terapisë me antibiotikë dhe të paktën 3-4 orë pas pastrimit të fundit ose fryrjes së hundës. Më së miri do të ishte që për ekzaminim mikrobiologjik të mblidhni sekret nga hunda, veçanërisht nëse është i dendur dhe me ngjyrë, pasi që është tipike për infeksion bakterial, ndryshe nga sekreti i tejdukshëm dhe i hollë që zakonisht transmeton infeksionin viral. Gjatë marrjes së brisit nga fyti dhe hunda te fëmijët, prindërit duhet ta mbajnë fëmijën në prehër, të vendosin njërën dorë te duart e fëmijës, ndërsa dorën tjetër te balli duke e mbajtur kështu kokën derisa personi adekuat i merr bris.
 KOLLITJA (sputum) – mostra nga kollitja për analiza mikrobiologjike më së miri është të merret në mëngjes, para se të merrni ushqim ose para se të pastroni gojën me mjete dezinfektuese dhe, sigurisht, para fillimit të terapisë me antibiotikë. Goja fillimisht shpëlahet me ujë të thjeshtë, i cili pështyhet, dhe më pas pacienti kollitet thellë në një enë sterile. Paralelisht me analizën e sputumit, duhet të bëhet edhe brisi i zgavrës së gojës.
KOLLITJA (sputum) – mostra nga kollitja për analiza mikrobiologjike më së miri është të merret në mëngjes, para se të merrni ushqim ose para se të pastroni gojën me mjete dezinfektuese dhe, sigurisht, para fillimit të terapisë me antibiotikë. Goja fillimisht shpëlahet me ujë të thjeshtë, i cili pështyhet, dhe më pas pacienti kollitet thellë në një enë sterile. Paralelisht me analizën e sputumit, duhet të bëhet edhe brisi i zgavrës së gojës.

 BRIS NGA KONJUKTIVA për analiza bakteriologjike më së miri është të merret në mëngjes, para tualetit të mëngjesit, me njomjen e brisit në një solucion fiziologjik steril me lëvizje anësore në mediale përgjatë anës së brendshme të kapakut të poshtëm. Brisi nga konjuktiva për ekzaminimin e pranisë së klamidisë gjithashtu merret në mëngjes, para tualetit të mëngjesit, me bris të thatë me lëvizje më agresive nga anësore në mediale përgjatë anës së brendshme të kapakut të poshtëm, për të marrë një shtresë epiteliale të kapakut ashtu siç do të ishin izolur klamiditë që gjenden në të.
BRIS NGA KONJUKTIVA për analiza bakteriologjike më së miri është të merret në mëngjes, para tualetit të mëngjesit, me njomjen e brisit në një solucion fiziologjik steril me lëvizje anësore në mediale përgjatë anës së brendshme të kapakut të poshtëm. Brisi nga konjuktiva për ekzaminimin e pranisë së klamidisë gjithashtu merret në mëngjes, para tualetit të mëngjesit, me bris të thatë me lëvizje më agresive nga anësore në mediale përgjatë anës së brendshme të kapakut të poshtëm, për të marrë një shtresë epiteliale të kapakut ashtu siç do të ishin izolur klamiditë që gjenden në të.
 URINOKULTURA është analiza më e zakonshme në mikrobiologji. Përgatitja për dhënien e urinës për urinokulturën është veçanërisht e rëndësishme te gratë dhe fëmijët e vegjël. E nevojshme është të pastroni organet gjenitale të jashtme me ujë të vakët dhe sapun. Pastaj lëkura duhet të thahet, pa aplikuar asnjë krem. Përgatitja për dhënien e urinës për urinokulturën tek meshkujt gjithashtu përfshin larjen e organeve gjenitale me ujë të ngrohtë dhe sapun. Vëmendje e veçantë duhet t’u kushtohet fëmijëve, duke e kthyer lëkurën në lafshë dhe pastaj ta lani. Meqenëse urina e parë praktikisht i pastron bakteret e lëkurës dhe florën bakteriale të uretrës, në një enë sterile merret urina e dytë, e cila është e mjaftueshme për të mbushur gotën në një të tretën e vëllimit. Te fëmijët gjithashtu është e dëshirueshme që të sigurohen kushte në mënyrë që ato të urinojnë direkt në enën sterile, por nëse kjo nuk është e mundur, duhet të lahen organet gjenitale të jashtme, të vendoset një qese dhe të kontrollohet kur fëmija urinon. Qeska mund të qëndrojë e ngjitur më së shumti deri në 15 minuta. Nëse fëmija nuk urinon gjatë kësaj kohe, qesja duhet të zëvendësohet me një të re. Kur fëmija urinon në qese, nëse kjo është e mundur në kushte shtëpie, duhet të transferohet menjëherë në një enë sterile për urinokulturë dhe të dërgohet në laboratorin mikrobiologjik për analiza sa më shpejt që të jetë e mundur (2 orë).
URINOKULTURA është analiza më e zakonshme në mikrobiologji. Përgatitja për dhënien e urinës për urinokulturën është veçanërisht e rëndësishme te gratë dhe fëmijët e vegjël. E nevojshme është të pastroni organet gjenitale të jashtme me ujë të vakët dhe sapun. Pastaj lëkura duhet të thahet, pa aplikuar asnjë krem. Përgatitja për dhënien e urinës për urinokulturën tek meshkujt gjithashtu përfshin larjen e organeve gjenitale me ujë të ngrohtë dhe sapun. Vëmendje e veçantë duhet t’u kushtohet fëmijëve, duke e kthyer lëkurën në lafshë dhe pastaj ta lani. Meqenëse urina e parë praktikisht i pastron bakteret e lëkurës dhe florën bakteriale të uretrës, në një enë sterile merret urina e dytë, e cila është e mjaftueshme për të mbushur gotën në një të tretën e vëllimit. Te fëmijët gjithashtu është e dëshirueshme që të sigurohen kushte në mënyrë që ato të urinojnë direkt në enën sterile, por nëse kjo nuk është e mundur, duhet të lahen organet gjenitale të jashtme, të vendoset një qese dhe të kontrollohet kur fëmija urinon. Qeska mund të qëndrojë e ngjitur më së shumti deri në 15 minuta. Nëse fëmija nuk urinon gjatë kësaj kohe, qesja duhet të zëvendësohet me një të re. Kur fëmija urinon në qese, nëse kjo është e mundur në kushte shtëpie, duhet të transferohet menjëherë në një enë sterile për urinokulturë dhe të dërgohet në laboratorin mikrobiologjik për analiza sa më shpejt që të jetë e mundur (2 orë).
Më së miri është që mostra e urinës të merret në mëngjes, pasi që pacienti nuk urinon natën para se të japë urinë.

Meqenëse urina është një lëndë ushqyese e mirë për zhvillimin e baktereve, ajo duhet të dorëzohet në laborator sa më shpejt të jetë e mundur ose të ruhet në frigorifer deri sa të merret në laborator. Nëse higjena gjenitale nuk është siç duhet ose nëse urina ka qendruar në temperaturë dhome për një kohë të gjatë, në mostër do të shfaqen një numër bakteresh të përziera nga flora e lëkurës, vaginale ose ajo e zorrëve. Nëse pacienti ka urinuar shumë herë gjatë natës dhe nëse nuk kanë kaluar më shumë se 4 orë që nga urinimi i fundit, numri i baktereve të izoluara në urinë mund të jetë më i ulët se sa që është në të vërtetë ose nëse bëhet fjalë për numër të vogël bakteresh, ato mund të mos izolohen.
Për ekzaminimin e pranisë së klamidisë, mikoplazmës ose ureaplazmës në urinë, është e nevojshme të jepet urina e parë, gjegjësisht urina e parë e mëngjesit, e cila zakonisht i mbledh qelizat epiteliale të uretrës, në të cilën gjenden këta mikroorganizma. Kjo kryesisht vlen për meshkujt, pasi që te femrat për izolimin e këtyre mikroorganizmave merret bris nga qafa e mitrës. Nëse dyshohet për uretritin, qoftë i shkaktuar nga bakteret, klamidia, mikoplazma apo ureaplazma, merret bris nga uretra edhe atë në mëngjes para urinimit, nëse kjo nuk është e mundur, atëherë në çfarëdo kohë mbrenda ditës, por në mënyrë që midis urinimit të fundit dhe marrjes së brisit të kenë kaluar së paku 2 orë.
BRIS VAGINAL DHE CERVIKAL – Pacientja nuk duhet të ketë mardhënie seksuale 24 orë para se t’i merren brisat. Këto lloje brisa merren nga personi profesional, kompetent (gjinekolog).
SPERMOGRAM – Analiza e spermogramit kërkon një abstenim prej 3 deri 5 ditë. Mostra e spermës jepet në laborator ose dërgohet në laborator me valixhe të veçanta transporti në 37 gradë Celsius brenda 20 minutash.
SPERMOKULTURA – Për spermokulturën, pacienti duhet të urinojë përpara se të jap mostrën e spermës. Për shkak të saktësisë së interpretimit të gjetjeve, është më e përshtatshme që njëkohësisht të merret për analiza mikrobiologjike edhe urina, bris nga uretra dhe spermoklutura.

BRISI NGA PLAGA është mirë që të merret para dhe pas mbështjelljes me fashë (trajtimi kirurgjikal i plagës) për të marrë të dhëna për thellësinë e infeksionit ekzistues.
MATERIALI FEÇE për ekzaminimin bakteriologjik duhet të dorëzohet në laboratorin mikrobiologjik në një enë sterile, në një periudhë të shkurtër kohore që nuk i tejkalon dy orë. Nëse nuk mund të dorëzohet në laborator gjatë kësaj kohe, mostra duhet të transportohet në frigorifer.
BRISI PERIANAL – Pastrimi bëhet natën para gjumit. Materiali merret në mëngjes, pasi të zgjoheni, para se të pastroheni dhe të urinoni, me ndihmën e një shirit ngjitës transparent me gjatësi prej 5 deri 7 cm (shirit ngjitës) i cili ngjitet me kujdes në zonën anale, ndërsa më pas ngjitet në xhamin për mostra, pa i prekur skajet dhe pa flluska ajri. E njëjta procedurë është e dëshirueshme që të përsëritet tre mëngjese të njëpasnjëshme dhe të dorëzohet në laborator si tre mostra të ndryshme.



















